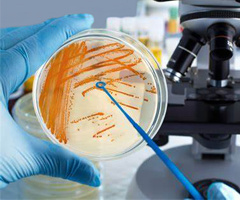

產(chǎn)品中心更多分類
微生物學(xué)儀器
-

大容量低溫離心機(jī)
3-6L大容量菌體離心 | 立式/臺(tái)式
了解更多大容量低溫離心機(jī)通常指Beckman Avanti J-26S XP、Avanti JXN-26、日立Himac CR-22N、Thermo Mutifuge X4R Pro,eppendorf 5920R、5810R這類可配置容量6×500mL以上高速角轉(zhuǎn)頭或容量4×750mL以上水平轉(zhuǎn)頭、可實(shí)現(xiàn)單次處理3L以上樣品通量的臺(tái)式/落地高速/低速低溫離心機(jī),常用于生物工程實(shí)驗(yàn)室發(fā)酵菌液離心收集、大量質(zhì)粒抽提和蛋白沉淀離心等應(yīng)用。
-

厭氧工作站
技術(shù)規(guī)格及安裝運(yùn)行條件 | 催化劑等配套耗材
了解更多厭氧工作站集樣品處理、制備和培養(yǎng)為一體,可提供穩(wěn)定的無氧、恒溫、恒濕條件,滿足厭氧微生物接種培養(yǎng)、分離鑒定工作需求。本欄目提供英國DWS35、英國Electrotek AW400TG、江雪Basic I/E200/E400/E500A、磐麥CAW200/CAW400、龍躍LAI-3DT等主流品牌熱銷型號(hào)的商品詳情。
-

微需氧工作站
微生物/細(xì)胞微需氧培養(yǎng) | 選型/安裝條件/維護(hù)耗材
了解更多微需氧工作站可以精確控制實(shí)驗(yàn)環(huán)境中的O2(0-20%)、CO2(0-15%)和H2(0.0-5.0%)的含量及溫濕度條件,可用于微需氧微生物(如幽門螺桿菌、硫酸鹽還原細(xì)菌等)、微需氧寄生蟲、哺乳動(dòng)物細(xì)胞的培養(yǎng)、造模實(shí)驗(yàn)。
-
微生物培養(yǎng)
微生物培養(yǎng)/接種 | 發(fā)酵罐
了解更多本欄目提供包括賽默飛Heratherm IMH60-S IMH100-S IMH180-S系列高精度控溫帶滅菌功能的微生物培養(yǎng)箱、BPH-9082/BPH-9162精密恒溫培養(yǎng)箱、LRH-100CL LRH-150CL低溫細(xì)菌培養(yǎng)箱、Biostat B-DCU發(fā)酵罐、微生物螺旋接種儀等國內(nèi)外品牌微生物接種、培養(yǎng)器專業(yè)設(shè)備信息。
-

微生物檢測
生化分子鑒定 | 菌落數(shù)量形態(tài)檢測
了解更多本欄目提供微生物自動(dòng)菌落計(jì)數(shù)儀、抑菌圈測量儀、微生物生長曲線自動(dòng)監(jiān)測系統(tǒng)、微生物生化鑒定系統(tǒng)、微生物鑒定及藥敏分析系統(tǒng)、微生物采樣器和菌種克隆篩選儀等進(jìn)口、國產(chǎn)微生物檢測裝備信息。




